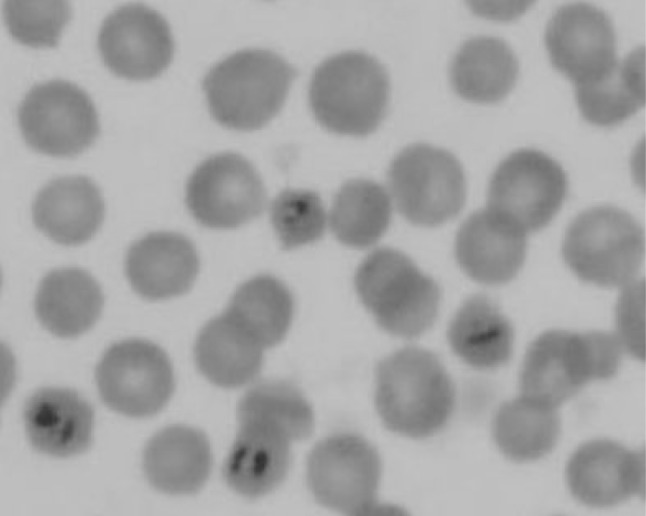

Abstract
Bovine babesiosis is an important tick-borne disease caused by the parasites belonging to the genus Babesia, distributed worldwide and infecting a wide range of domesticated and wild cattle, occasionally man. The present study was conducted to determine the prevalence of B. bigemina infection in apparently healthy cattle from central plain zone of Punjab, India. Examination of Giemsa-stained peripheral thin blood smears revealed 2.45 % (5/204) animals to be positive for piroplasms of B. bigemina. However, genomic DNA isolated from these blood samples when subjected to primary PCR revealed a positivity of 7.35 % (15/204) as detected by the amplification of a 278-bp product in the agarose gel. PCR products obtained from the primary PCR of B. bigemina, when employed as template in nested PCR produced the amplicons of desired size (170 bp) was detected in 30.39 % (62/204) of the samples. It can thus be concluded that B. bigemina infection is prevalent in apparently healthy cattle population of this region and PCR assays can serve as a valuable tool for epidemiological studies in endemic areas.
Keywords: Babesia bigemina, Cattle, Microscopy, Nested-PCR, Prevalence, Punjab
Introduction
Bovine babesiosis is an important intra-erythrocytic apicomplexan tick-borne haemoprotozoan disease caused by the parasites of the genus Babesia, distributed worldwide, infecting a wide range of domesticated and wild cattle, occasionally man (McCrosker 1981). Among various species, B. bigemina is the most common species infecting cattle in tropical and sub-tropical regions of the world including Indian subcontinent. The parasite is transmitted transovarially by the larval stages of Rhipicephalus (Boophilus) microplus ticks (Chauvin et al. 2009). Losses due to babesiosis to the livestock industry are enormous and are incurred from mortality, ill-thrift, loss of milk/meat production, draft power, cost on control measures, and also through its impact on international cattle trade (Bock et al. 2004). India suffers losses of about 57.2 million US dollars annually due to impact of babesiosis and anaplasmosis on livestock and its control (McLeod and Kristjanson 1999). Further, with the recent reports of replacement of multi-host tick (Hyalomma anatolicum anatolicum) by one host tick (R. (B.) microplus) in dairy animals of Punjab state, there is an increased concern over the diseases transmitted by the one host tick especially B. babesiosis and anaplasmosis (Singh and Rath 2013).
Diagnosis of bovine babesiosis by microscopy still remains the “gold standard” but lacks sensitivity (Bose et al.1995). Alternative diagnostic approaches like indirect fluorescent antibody test (IFAT) and enzyme-linked immunosorbent assay (ELISA) are capable of detecting the antibody in carrier animals but suffer serious drawbacks of cross-reaction between B. bigemina and B. bovis and the lack of discrimination between previous exposure and current infections (Wagner et al. 1992). However, recently a number of molecular techniques have been described that can detect and differentiate various species of Babesia in carrier animals (Oliveira et al. 2005; Buling et al. 2007; Ravindran et al. 2008; Singh et al. 2010). The application of PCR-based assays for epidemiological studies of babesiosis is still incipient, but its characteristics of high sensitivity and specificity have been verified by several authors for the detection of infection (Almeria et al. 2001; Oliveira et al. 2005; Ravindran et al. 2008; Singh et al. 2010). Nested PCR based studies to ascertain the status of babesiosis in healthy carrier animals exhibiting low parasitaemia has not been carried yet, especially from this part of the country. Therefore, the present study was planned to study the prevalence of B. bigemina infection in apparently healthy cattle from central plain zone of Punjab by employing both conventional and molecular techniques.
Materials and methods
Geographical area
The study was conducted from central plain zone of Punjab state covering an area of 18,000 km2 and comprising of 8 districts viz: Amritsar, Tarn Taran, Kapurthala, Jalandhar, Ludhiana, Fatehgarh Sahib, Sangrur and Patiala. The climate of the region is subtropical, the annual rainfall is 500-800 mm and average maximum and minimum temperatures are 41–42 °C and 4–7 °C, respectively. These climatic conditions provide favourable and conducive environment for the optimal development and propagation of the vector ticks involved in the transmission of various haemoprotozoan diseases. The major tick species reported infesting cross bred cattle from central plain zone of Punjab state are R. (B.) microplus and H. a. anatolicum (Haque et al. 2011; Singh and Rath 2013).
Sample collection
Blood samples (n = 204) were collected from apparently healthy cattle from district Amritsar (18), Tarn Taran (14), Kapurthala (21), Jalandhar (37), Ludhiana (45), Fatehgarh Sahib (12), Sangrur (30) and Patiala (27) from June, 2011 to May, 2013 aseptically in a vacutainer containing 3.2 % sodium citrate as anticoagulant. From the blood samples of all the selected animals, peripheral thin blood smears were made directly after ear puncture, air dried, fixed in methyl alcohol for 2 min and brought to laboratory for further processing. Staining of fixed smears was done with working dilution of 10 % Giemsa stain for 30 min. The smears were then washed with tap water to remove extra stain, air dried and examined under oil immersion for demonstration of Babesia piroplasms, if any. The blood samples were further stored at −20 °C for DNA extraction.
Genomic DNA isolation
For conducting the PCR assay, whole-genomic DNA was isolated from blood sample using QIAamp® DNA blood mini kit (QIAGEN, GmbH, Germany) following the manufacturer’s recommendations with minor modifications as per Singh et al. (2012a). In brief, approximately 200 μl of the blood sample was mixed with 25 μl of proteinase-K and 200 μl of lysis buffer in a 2.0 ml microcentrifuge tube. The homogenous suspension was thoroughly vortexed and incubated at 56 °C for 15 min and then centrifuged for 30 s at 5,000 rpm. Subsequently, 200 μl of ethanol was added to the lysate and again vortexed. The mixture was then applied to QIAamp spin column and centrifuged at 8,000 rpm for 1.5 min. Thereafter, two washings were given with wash buffers and DNA was eluted in 150 μl of elution buffer and stored at −20 °C till further use. Genomic DNA of B. bigemina was isolated from infected blood showing high parasitaemia in Giemsa stained blood smear examination and utilized as positive control. Genomic DNA was also isolated from the whole blood of infection-free, 3-day-old bovine calf and used as a negative control.
PCR assays
The primary and nested PCR assays were carried out using the sequences of oligonucleotide primers specific for B. bigemina as described by Figueroa et al. (1992). The sequences of the primers are as follows:
BiIA: 5′-CAT CTA ATT TCT CTC CAT ACC CCT CC-3′
BiIB: 5′-CCT CGG CTT CAA CTC TGA TGC CAA AG-3′
BiIAN 5′-CGC AAG CCC AGC ACG CCC CGG TGC-3′
BiIBN 5′-CCG ACC TGG ATA GGC TGT GTG ATG-3′
Two rounds of PCR in a final volume of 25 μl were carried out in a PCR thermal cycler (Eppendorf, Germany). In the primary PCR assay, the master solution consisted of 2.5 μl of 10× PCR buffer (MBI Fermentas), 0.5 μl of 10 mM dNTP mix (MBI Fermentas), 2.0 μl of 25 mM MgCl2 (MBI Fermentas), 1.0 U of recombinant Taq DNA polymerase (MBI Fermentas), 1 μl each (15 pmol) of the external forward and external reverse primers and 5 μl of template DNA isolated from field samples. The volume was made up to 25 μl with nuclease-free water. The cycling conditions were as: Initial denaturation at 94 °C for 5 min, 37 cycles of denaturation at 94 °C for 1 min, annealing at 59 °C for 1 min, and extension at 72 °C for 1 min, and the final extension was performed at 72 °C for 10 min. In order to carry out the nested PCR, the PCR conditions were the same as described above, but instead of template DNA, 1 μl of the primary PCR product was used as template and amplified with 15 pmol, each of the internal forward and the internal reverse primers and annealing temperature was kept at 70 °C. The PCR products (primary as well as nested) were checked for amplification by electrophoresis on a 1.5 % agarose gel and visualized using gel documentation system (Syngene, UK). In order to check the specificity of the assay, genomic DNA of Theileria annulata, Anaplasma marginale and Trypanosoma evansi isolated from the microscopically positive cases by standard protocols were also employed in the PCR to see the amplification, if any. The results of PCR assay were compared with that of Giemsa-stained blood smear examination.
Statistical analysis
Statistical analysis was performed on data by SPSS 13.0 software by applying Chi Square test.
Results
Examination of Giemsa-stained peripheral thin blood smears of apparently healthy cattle from central plain zone of Punjab state revealed 2.45 % (5/204) animals positive for piroplasms of B. bigemina (Fig. 1). Further, in order to assess the true status of B. bigemina infection in apparently healthy cattle, all the samples were analysed initially by primary PCR followed by nested PCR, to detect any amplification in the form of ethidium bromide-stained amplicons, after standardization of the assays. Of the total samples subjected to primary PCR, 7.35 % (15/204) were found to be positive for B. bigemina infection as revealed by the amplification of a 278-bp product (Fig. 2). PCR products obtained from the primary PCR of B. bigemina, when employed as template in nested PCR produced the amplicons of desired size (170 bp) was observed in 30.39 % (62/204) of the samples (Fig. 3). This validates that nested PCR, when coupled with primary PCR, results in increased sensitivity of the assay, as the products from the primary PCR (47 samples) that were not visualized in the ethidium bromide-stained agarose gel electrophoresis, when subjected to nested PCR, could be detected. Regarding sensitivity of nested PCR, it was observed that amplification was achieved even from those primary PCR products that could not be visualized on agarose gel electrophoresis. The PCR primers used in the present assay did not amplify any product when the genomic DNA of T. annulata, A. marginale and T. evansi were used as template revealing the specificity of these primers for detection of B. bigemina infections in carrier cattle.
Fig. 1.
Babesia bigemina piroplasms in Giemsa stained blood smear examination at oil immersion
Fig. 2.
Amplification of 278-bp fragment of Babesia bigemina by primary PCR. Lane L 100 bp DNA ladder, lane P positive control, lane N negative control, lanes A–C field collected blood samples
Fig. 3.
Amplification of 170-bp fragment of Babesia bigemina by nested PCR. Lane L 100 bp DNA ladder, lane P positive control, lane N negative control, lanes A–C field collected blood samples
Discussion
Results obtained by blood smear examination in the present study reveal a low prevalence rate (2.45 %) of B. babesiosis which corroborates with the findings of Singh et al. (2012b) who reported a 1.56 % prevalence of babesiosis in cattle from the same region and Muraleedharan et al. (2005) who recorded 2.19 % prevalence from Karnataka state. However, Aulakh et al. (2005) reported a much higher infection rate of 8.33 % in cattle of Punjab using blood smear examination which was probably due the fact that the samples utilized in the study were taken from animals suspected for babesiosis and showing clinical signs of persistent fever. Further, variable incidence rates of babesiosis ranging from 0.76 to 18.50 % had been reported from various parts of the country (Yadav et al. 1985; Mallick et al. 1987; Sharma et al. 2000). Results of current study show a low level of piroplasms in the peripheral blood indicating the carrier status of the animals examined. Such carrier animals are poor in productivity leading to huge economic losses to the livestock owners and also act as important contributors to transmission of disease to susceptible animals through vector ticks. Thus, detection of infection in such carrier animals becomes an important epidemiological parameter and would be of utmost help in designing better and effective control strategies against the disease (d’Oliveira et al. 1995).
PCR based assay for sensitive diagnosis of B. babesiosis has been attempted by many workers with high degree of sensitivity and specificity worldwide (Fahrimal et al. 1992; Salem 1998; Smeenk et al. 2000; Santana et al. 2001; Linhares et al. 2002; Silva et al. 2009; Brito et al. 2010; Shams et al. 2013). A PCR based assay for sensitive detection of B. bigemina was originally described by Figueroa et al. (1992), targeting 278 bp fragment specific of parasite DNA. Recently, in similar study 34 % infection rate of B. bigemina has been reported in clinically healthy animals from different districts from Central and Southern regions of Portugal (Silva et al. 2009). However, a comparatively higher prevalence of B. babesiosis has been reported from various regions viz: Pakistan (29 %) by Chaudhry et al. (2010), Zimbabwe (35 %) by Smeenk et al. (2000) using PCR assays. A very high sensitivity of PCR/nPCR for the detection of B. bigemina was reported by Oliveira et al. (2005) in both cattle and R. microplus and Silva et al. (2009) in cattle. In India, only few reports employing PCR based assay to know the status of the disease are available from different areas of the country (Ravindran et al. 2002; Singh et al. 2007, 2013; Nair et al. 2011).
In principle, the occurrence of B. bigemina in cattle is largely dependent on the distribution of tick vectors (de Vos 1979). Recent studies on epidemiology and distribution of tick species in Punjab showed R. microplus to be the predominant tick which is responsible for transmission of B. bigemina in cattle and buffaloes (Haque et al. 2011; Singh and Rath 2013). Also, a high degree of sero-prevalence (59.47 %) has been reported using IFAT in female cattle of Ludhiana district of Punjab (Singh et al. 2007). Therefore, owing to the higher sensitivity of nested PCR (Oliveira et al. 2005) and abundance of specific vector, higher prevalence value of B. bigemina infection in the cattle of Punjab is not surprising. B. bigemina is protozoa of major concern in Indian cattle herds, parasitizing both cattle and buffaloes (Muraleedharan et al. 1984). Further, buffaloes might serve as reservoirs for the infections of cattle, since they are together in the dairy farms and continue to infect the tick vector (Bock et al. 2004).
Although, microscopic techniques are best suited to diagnose acute babesiosis but has limited application for detection of the parasite in carrier animals recovering from acute condition and exhibiting low parasite numbers in the peripheral blood. The higher sensitivity of PCR-based techniques compared to other diagnostic techniques, for the diagnosis of Babesia species has been reported by different workers (reviewed by Sparagano 1999). In the present study, the PCR assays revealed significantly higher sensitivity in detection of babesiosis in apparently healthy cattle than the microscopic examination (62 animals for nested PCR and 15 for primary PCR versus 5, respectively, p < 0.01).
It can hence be concluded that B. bigemina is highly prevalent in apparently healthy cattle of this region thus indicating an endemic situation in the region. The nested PCR assay can detect B. bigemina infection even at low parasitemia routinely exhibited in apparently healthy animals and can serve as a valuable tool under field conditions.
Acknowledgments
Authors are thankful to The Dean, Postgraduate Studies, Guru Angad Dev Veterinary and Animal Sciences University, Ludhiana for providing facilities to carry out the research work.
References
- Almeria S, Castella J, Ferrer D, Ortuno A, Estrada-Pena A, Gutierrez JF. Bovine piroplasms in minorca (Balearic Islands Spain): a comparison of PCR-based and light microscopy detection. Vet Parasitol. 2001;99:249–259. doi: 10.1016/S0304-4017(01)00464-2. [DOI] [PubMed] [Google Scholar]
- Aulakh GS, Singla LD, Kaur P, Alka Bovine babesiosis due to Babesia bigemina: haematobiochemical and therapeutic studies. Indian J Anim Sci. 2005;75:617–622. [Google Scholar]
- Bock R, Jackson L, de Vos A, Jorgensen W. Babesiosis of cattle. Parasitology. 2004;129:247–269. doi: 10.1017/S0031182004005190. [DOI] [PubMed] [Google Scholar]
- Bose R, Jorgensen WK, Dalgliesh RJ, Friedhoff KT, De Vos AJ. Current and future trends in the diagnosis of babesiosis. Vet Parasitol. 1995;57:61–74. doi: 10.1016/0304-4017(94)03111-9. [DOI] [PubMed] [Google Scholar]
- Brito LG, de Oliveira MCS, Rocha RB, da Silva FG, Marim AD, de Souza GCR, Vendrame FB, da Moura MMF. Anaplasma marginale infection in cattle from south-western Amazonia. Pesquisa Vet Brasil. 2010;30:249–254. doi: 10.1590/S0100-736X2010000300011. [DOI] [Google Scholar]
- Buling A, Criado-Fornelio A, Asenzo G, Benitez D, Barba-Carretero JC, Florin-Christensen M. A quantitative PCR assay for the detection and quantification of Babesia bovis and B. bigemina. Vet Parasitol. 2007;147:16–25. doi: 10.1016/j.vetpar.2007.03.031. [DOI] [PubMed] [Google Scholar]
- Chaudhry ZI, Suleman M, Younus M, Aslim A. Molecular detection of Babesia bigemina and Babesia bovis in crossbred carrier cattle through PCR. Pak J Zool. 2010;42:201–204. [Google Scholar]
- Chauvin A, Moreau E, Bonnet S, Plantard O, Malandrin L. Babesia and its hosts: adaptation to long-lasting interactions as a way to achieve efficient transmission. Vet Res. 2009;40:37. doi: 10.1051/vetres/2009020. [DOI] [PMC free article] [PubMed] [Google Scholar]
- d’Oliveira C, van der Weide M, Habela MA, Jacquiet P, Jongejan F. Detection of Theileria annulata in blood samples of carrier cattle by PCR. J Clin Microbiol. 1995;33:2665–2669. doi: 10.1128/jcm.33.10.2665-2669.1995. [DOI] [PMC free article] [PubMed] [Google Scholar]
- de Vos AJ. Epidemiology of Bovine babesiosis in South Africa. Onderstepoort J Vet Res. 1979;50:357–362. [PubMed] [Google Scholar]
- Fahrimal Y, Goff WL, Jasmer DP. Detection of Babesia bovis carrier cattle by using polymerase chain reaction amplification of parasite DNA. J Clin Microbiol. 1992;30:1374–1379. doi: 10.1128/jcm.30.6.1374-1379.1992. [DOI] [PMC free article] [PubMed] [Google Scholar]
- Figueroa JV, Chieves LP, Johnson GS, Buening GM. Detection of Babesia bigemina infected carriers by polymerase chain reaction amplification. J Clin Microbiol. 1992;30:2578–2582. doi: 10.1128/jcm.30.10.2576-2582.1992. [DOI] [PMC free article] [PubMed] [Google Scholar]
- Haque M, Jyoti Singh NK, Rath SS, Ghosh S. Epidemiology and seasonal dynamics of Ixodid ticks of dairy animals of Punjab state, India. Indian J Anim Sci. 2011;81:661–664. [Google Scholar]
- Linhares GFC, Santana AP, Laueman LH, Madruga CR. Assessment of primers designed from the small ribosomal subunit RNA for specific discrimination between Babesia bigemina and Babesia bovis by PCR. Ciencia Anim Bras. 2002;3:27–32. [Google Scholar]
- Mallick KP, Dwivedi SK, Srivastava NK, Kumar S. A report on the occurrence of haemoprotozoan infection in rural livestock. Indian J Parasitol. 1987;11:25–26. [Google Scholar]
- McCrosker . The global importance of babesiosis. New York: Academic Press Inc; 1981. pp. 1–24. [Google Scholar]
- Mcleod R, Kristjanson P. Final report of joint esys/ILRI/ACIAR TickCost project-economic impact of ticks and tick-borne diseases to livestock in Africa. Nairobi: International Livestock Research Institute; 1999. [Google Scholar]
- Muraleedharan K, Ziauddin KS, Gopalaswamy K, Muraleedhar T, Seshadri SJ. Some observations on clinical cases of Babesia bovis (BABES, 1888) Starcovici, 1893, in buffaloes (Bubalus bubalis) Indian Vet J. 1984;61:76–79. [Google Scholar]
- Muraleedharan K, Ziauddin KS, Hussain PM, Pattabyatappa B, Mallikarjun GB, Seshadri SJ. Incidence of Anaplasma sp., Babesia sp. and Trypanosoma sp. in cattle of Karnataka. J Vet Parasitol. 2005;19:135–137. [Google Scholar]
- Nair AS, Ravindran R, Lakshmanan B, Kumar SS, Tresamol PV, Saseendranath MR, Senthilvel K, Rao JR, Tewari AK, Ghosh S. Haemoprotozoa of cattle in northern Kerala, India. Trop Biomed. 2011;28:68–75. [PubMed] [Google Scholar]
- Oliveira MCS, Oliveira-Sequeira TCG, Araujo JP, Jr, Amarante AFT, Oliveira HN. Babesia spp. infection in Boophilus microplus engorged females and eggs in Sao Paulo State, Brazil. Vet Parasitol. 2005;130:61–67. doi: 10.1016/j.vetpar.2005.03.007. [DOI] [PubMed] [Google Scholar]
- Ravindran R, Mishra AK, Rao JR. On the high seroprevalence of Bovine babesiosis in Wyanad district of Kerala. J Appl Anim Res. 2002;22:43–48. doi: 10.1080/09712119.2002.9706377. [DOI] [Google Scholar]
- Ravindran R, Mishra AK, Rao JR. Randomly amplified polymorphic DNA-polymerase chain reaction fingerprinting of Babesia bigemina isolates of India. Vet Arhiv. 2008;78:545–551. [Google Scholar]
- Salem GH (1998) Using of ribosomal at DNA based PCR method for sensitive detection of carrier and mild babesial infections among cattle in Egypt. Assiut Vet Med J 39:92–108
- Santana AP, Linhares GFC, Borges GT, Mesquita AJ, Miranda AH, Madruga CR, Minharro SB. Diagnosis of Babesia bigemina by polymerase chain reaction using GAU6 and GAU7 primers for SSU rRNA fragment. Ars Vet. 2001;17:224–229. [Google Scholar]
- Shams S, Ayaz S, Ali I, Khan S, Gul I, Gul N, Khan SN. Sensitivity and specificity of PCR and microscopy in detection of Babesiosis in domesticated cattle of Khyber Pakhtunkhwa, Pakistan. Int J Adv Res Tech. 2013;2:37. [Google Scholar]
- Sharma AK, Katoch RC, Nagal KB, Kishtwaria RS, Sharma SK. Bovine babesiosis in Palampur Valley of Himachal Pradesh. Indian Vet J. 2000;77:731–732. [Google Scholar]
- Silva MG, Henriques G, Sanchez C, Marques PX, Suarez CE, Oliva A. First survey for Babesia bovis and Babesia bigemina infection in cattle from central and southern regions of Portugal using serological and DNA detection methods. Vet Parasitol. 2009;166:66–72. doi: 10.1016/j.vetpar.2009.07.031. [DOI] [PubMed] [Google Scholar]
- Singh NK, Rath SS. Epidemiology of ixodid ticks in cattle population of various agro-climatic zones of Punjab. Asian Pac J Trop Med. 2013;6:947–951. doi: 10.1016/S1995-7645(13)60169-8. [DOI] [PubMed] [Google Scholar]
- Singh H, Mishra AK, Rao JR, Cheema PS, Sankar M. Polymerase chain reaction for diagnosis of Babesia bigemina. Indian Vet J. 2007;84:346–348. [Google Scholar]
- Singh H, Cheema PS, Mishra AK, Tewari AK, Rao JR, Ravindran R, Ray D, Bansal GC. β-Tubulin gene based PCR-RFLP method for specific detection of Babesia bigemina and Theileria annulata isolates. J Appl Anim Res. 2010;37:233–238. doi: 10.1080/09712119.2010.9707131. [DOI] [Google Scholar]
- Singh H, Jyoti Haque M, Singh NK, Rath SS. Molecular detection of Anaplasma marginale infection in carrier cattle. Ticks Tick Borne Dis. 2012;3:55–58. doi: 10.1016/j.ttbdis.2011.10.002. [DOI] [PubMed] [Google Scholar]
- Singh NK, Singh H, Jyoti, Haque M, Rath SS. Prevalence of parasitic infections in cattle of Ludhiana district, Punjab. J Parasit Dis. 2012;36:256–259. doi: 10.1007/s12639-012-0119-y. [DOI] [PMC free article] [PubMed] [Google Scholar]
- Singh H, Jyoti, Haque M, Singh NK, Rath SS (2013) Polymerase chain reaction based detection of subclinical Bovine babesiosis in Punjab. Indian J Anim Res 47:543–546
- Smeenk I, Kelly PJ, Wray K, Musuka G, Trees AJ, Jongejan F. Babesia bovis and B. bigemina DNA detected in cattle and ticks from Zimbabwe by polymerase chain reaction. J S Afr Vet Assoc. 2000;71:21–24. doi: 10.4102/jsava.v71i1.671. [DOI] [PubMed] [Google Scholar]
- Sparagano O. Molecular diagnosis of Theileria and Babesia species. Vet Parasitol. 1999;13:83–92. [Google Scholar]
- Wagner G, Cruz D, Holman P, Waghela S, Perrone J, Shompole S, Rurangirwa F. Non-immunologic methods of diagnosis of babesiosis. Mem Inst Oswaldo Cruz. 1992;87:193. doi: 10.1590/S0074-02761992000700032. [DOI] [PubMed] [Google Scholar]
- Yadav CL, Gupta RP, Ruprah NS. Studies on protozoan infections in cattle and buffaloes. Indian Vet Med J. 1985;9:205–209. [Google Scholar]


